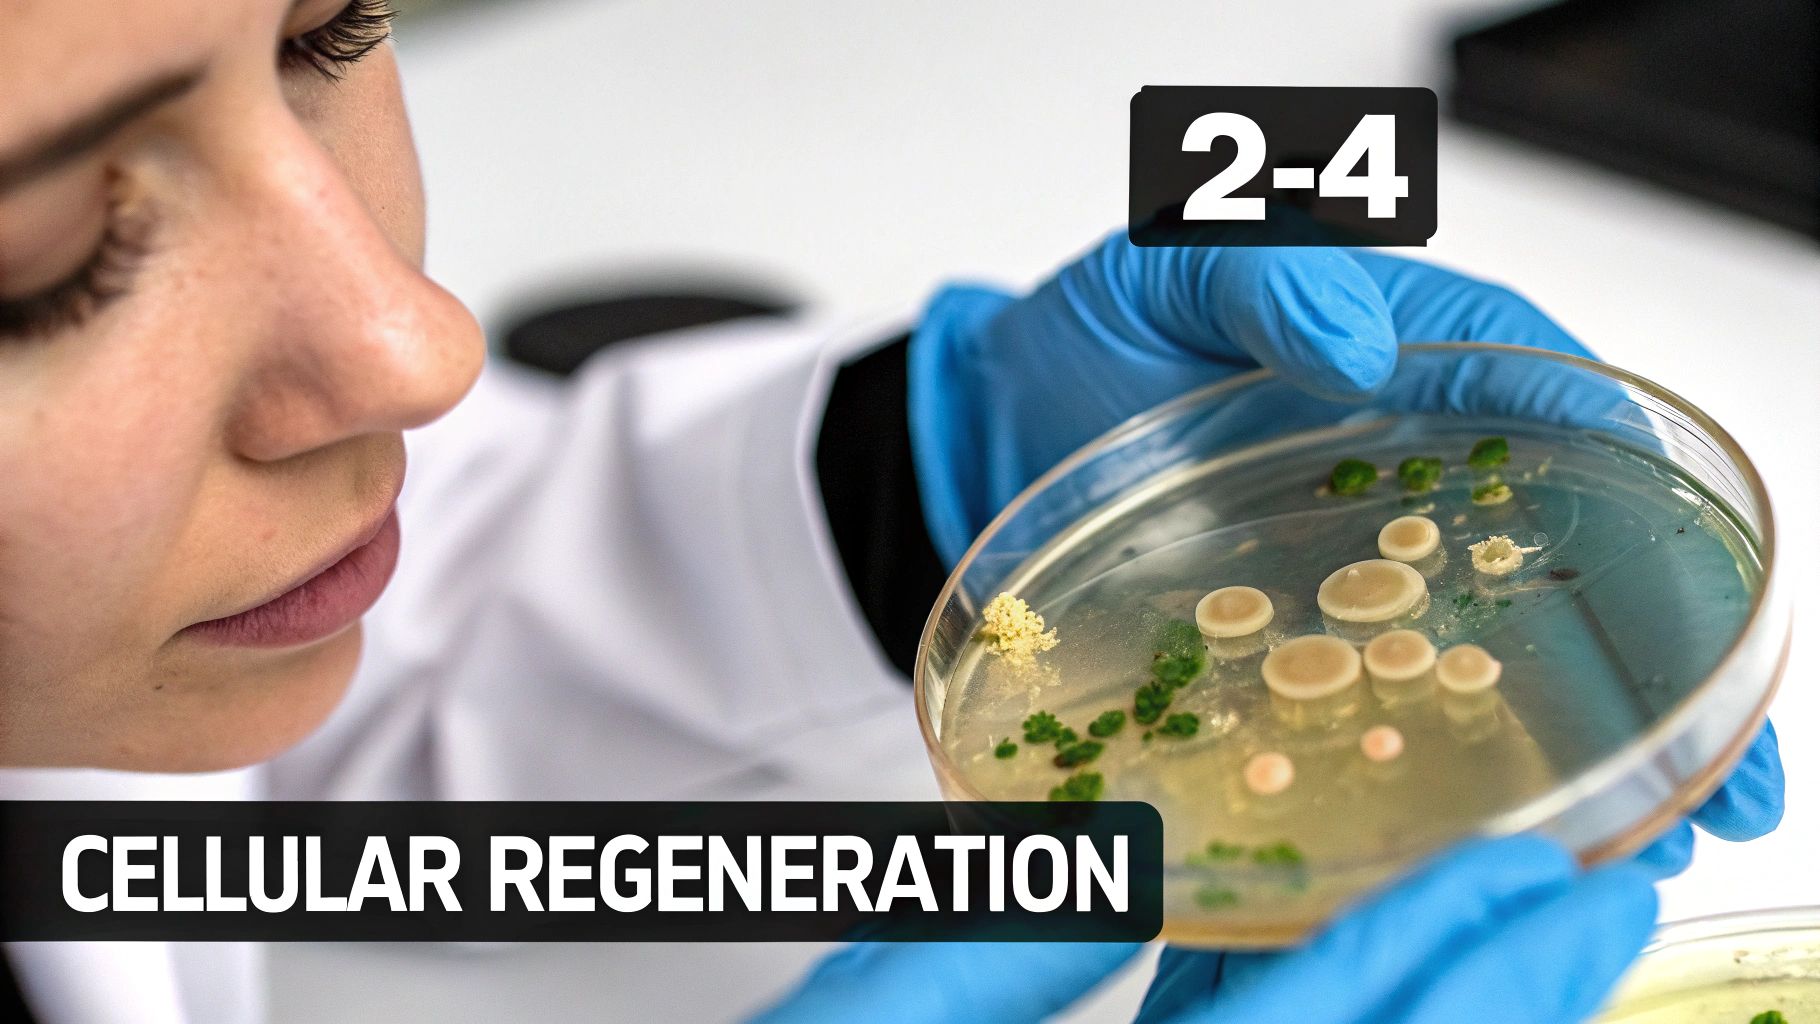
A scientist in blue gloves holds a petri dish with various microbial cultures, text 'CELLULAR REGENERATION'.

A Patient’s Guide to Stem Cell Therapies and Regeneration
When you hear the term stem cell therapies, what comes to mind? For many, it's a concept that feels both futuristic and complex. At its core, however, it is a sophisticated medical approach designed to harness one of the most powerful healing systems in existence: your own body.
These therapies represent a fundamental shift in medicine. Instead of managing symptoms with external solutions, we are now able to work from the inside out, utilizing the body's own master cells to repair damaged tissue, resolve inflammation, and restore physiological function. This is not about masking a problem; it's about addressing it at a cellular level.
A New Era of Healing and Regeneration

Welcome to the clinical application of regenerative medicine, a field where the body's innate intelligence becomes the most powerful tool for healing. The use of stem cell therapies is no longer a distant scientific theory—it is a clinical reality that is transforming our approach to health, recovery, and longevity.
The core principle is elegantly simple. The stem cells within your body are the original "master blueprints" for every other cell and tissue. These remarkable cells possess a unique ability to transform into any specialized cell the body requires, whether that is cartilage for a degenerative joint, muscle fibers for an injured tendon, or new skin to heal a wound.
Harnessing Your Body’s Potential
The objective of regenerative medicine is to strategically deploy this natural power. Rather than introducing foreign substances to quiet pain signals, we deliver a concentrated force of the body’s own healing agents directly to the areas that need them most. This process is designed to address the root cause of an issue, not merely its effects.
Before we explore this further, it is helpful to become familiar with the core components of modern regenerative treatments. Consider them the key players on your body's internal repair team.
Table of Contents
Key Concepts in Regenerative Medicine
Therapeutic AgentPrimary FunctionAnalogyMesenchymal Stem Cells (MSCs)Coordinate tissue repair and control inflammation.The construction managers of a building site, directing other cells on how and where to rebuild.ExosomesCarry instructions and materials between cells.The messengers delivering detailed blueprints and supplies from the managers to the workers.Natural Killer (NK) CellsRemove damaged or dysfunctional "senescent" cells.The demolition crew that clears away old, unstable structures so new construction can begin safely.
Each of these agents plays a critical, distinct role. By understanding how they work in concert, you can appreciate how a comprehensive regenerative strategy does far more than just patch up damage—it orchestrates a complete restoration.
Our entire philosophy is built on this foundation of biological intelligence, combining leading-edge science with meticulous, physician-led care. We believe true healing begins with clarity and confidence, which is why we place a strong emphasis on patient education. When you understand the power of regeneration, you can truly appreciate how these therapies support and amplify your body's natural systems.
By activating the body’s own repair mechanisms, stem cell therapies aim to rebuild what has been lost to injury, disease, or the passage of time. The focus is on creating a lasting biological improvement that enhances both function and quality of life.
The Longevity Medical Institute Approach
At Longevity Medical Institute, we have established a premium clinical setting where this advanced science is delivered with the highest standards of safety, ethics, and compassionate care. Our specialists will guide you through a carefully curated treatment plan designed specifically for your health objectives.
This guide will demystify the science, explain the process step-by-step, and provide the foundational knowledge you need as you explore the remarkable potential of regenerative medicine for your health.
How Stem Cells Drive Cellular Regeneration
At the heart of regenerative medicine lies a simple but profound biological truth: your body is designed to heal itself. Stem cells are the master conductors of this internal repair system, the foundational cells from which every other specialized cell in your body originates.
To fully grasp how stem cell therapies function, we must examine two unique properties that set them apart from all other cell types. These abilities are what make them so powerful in a clinical setting.
The Two Pillars of Stem Cell Power
First is their capacity for self-renewal. When a stem cell divides, it can create a perfect copy of itself. This ensures the body maintains a fresh supply of these critical repair cells, allowing for sustained healing over time.
Second is their power of differentiation. This is the remarkable process where an unspecialized stem cell transforms into a specific cell type the body requires—a cartilage cell for a worn joint, a muscle cell for a torn ligament, or a bone cell to mend a fracture. They are cellular chameleons, adapting on demand.
These two functions mean stem cells act as a dynamic reservoir for repair. They can either multiply to create more master cells or differentiate to become the exact building blocks needed to resolve damage.
The Healing Cascade in Action
When we introduce stem cells into an area of injury or degeneration, they do not just passively become new tissue. The process is far more sophisticated. Think of them less as simple bricks and more as the architects and project managers of a complex reconstruction project.
They orchestrate a coordinated healing cascade through several key actions:
- Calming Harmful Inflammation: Stem cells release potent anti-inflammatory signals that quiet the local environment. As chronic inflammation is a primary driver of pain and tissue breakdown, controlling it is the first step toward creating the right conditions for repair.
- Modulating the Immune System: They intelligently fine-tune the immune response, preventing it from overreacting and causing further damage. This is especially crucial in autoimmune conditions, where they can help shift the immune system from a destructive state to a pro-healing one.
- Signalling Local Cells: Stem cells act as communication hubs, releasing growth factors and signaling molecules (often packaged in tiny vesicles called exosomes). These signals serve as instructions that activate your body's own resident cells, encouraging them to participate in the rebuilding process.
- Promoting Angiogenesis: They support the formation of new blood vessels, a vital step for delivering the oxygen and nutrients that damaged tissues require to heal properly.
The true goal of regenerative medicine is not simply to mask symptoms; it is to address the underlying cause of the problem. By orchestrating this symphony of repair, stem cells aim to rebuild tissue, restore function, and create a lasting biological improvement.
Repair Versus True Regeneration
It is important to distinguish between simple repair and true regeneration. When you sustain a deep cut, your body forms a scar. That is repair. The scar tissue closes the wound, but it is not the same as the original, healthy skin.
Regeneration, conversely, is the process of creating the original, fully functional tissue. This is the level of healing we aim to achieve with advanced stem cell therapies. In an arthritic knee, for instance, the objective is not to create scar tissue in the joint but to rebuild healthy, smooth cartilage that restores function and eliminates pain at its source. This focus on functional restoration is what sets this approach apart.
Advanced Stem Cell Types and Delivery Methods
To design a truly effective treatment, we must begin with two fundamentals: selecting the right type of cells and delivering them with absolute precision. The world of stem cell therapies is not a one-size-fits-all discipline. It demands a deep understanding of cellular biology and a sophisticated approach to administration, where every clinical decision is guided by your unique physiology and health objectives.
At the heart of this process is the source of the stem cells themselves. We utilize two primary options, each offering distinct advantages for different clinical situations. Understanding this difference is the first step in appreciating the level of detail that informs your regenerative protocol.
Autologous vs. Allogeneic Cells: Your Body or a Donor?
The first option is using autologous cells, which are harvested directly from your own body—typically from adipose (fat) tissue or bone marrow. The main benefit is straightforward: there is zero risk of rejection because the cells are your own. This makes them an excellent choice for certain orthopedic and localized treatments.
The alternative is allogeneic cells, which come from a rigorously screened, healthy donor. We exclusively use cells derived from umbilical cord tissue, which is ethically sourced and contains some of the most potent and youthful stem cells available. These cells have a remarkable capacity for regeneration and do not express the markers that trigger an immune response, making them universally safe for all patients.
For most systemic conditions or advanced degenerative issues, allogeneic cells are our preferred choice. Their robust signaling capabilities and high viability are unmatched, particularly since a patient's own cells naturally decline in potency with age.
The choice between autologous and allogeneic cells is a clinical one, based on factors such as your age, the specific condition being treated, and your overall health. Our physicians determine the optimal source to ensure the highest potential for a successful outcome.
Mesenchymal Stem Cells: The Powerhouse of Regeneration
Our primary focus is on a specific type of adult stem cell known as the Mesenchymal Stem Cell (MSC). These cells are the undisputed powerhouses of regenerative medicine, celebrated for their potent anti-inflammatory and tissue-repair capabilities.
MSCs are masters of communication and orchestration within the body. When introduced, they perform several critical functions:
- They release powerful signals to calm chronic inflammation directly at the source.
- They intelligently modulate the immune system, down-regulating destructive responses.
- They signal your body’s own resident cells to initiate repair and rebuilding processes.
This multi-faceted action makes MSCs exceptionally effective for a wide range of conditions, from joint degeneration to systemic autoimmune disorders.
Precision Delivery for Maximum Efficacy
The method of administration is just as crucial as the cells themselves. To ensure the cells reach their target and can perform their function effectively, we use advanced and precise delivery techniques. The goal is always to maximize bioavailability and therapeutic impact.
We tailor the delivery method based on your specific treatment goals:
- Intravenous (IV) Infusion: For systemic conditions like autoimmune diseases or for overall anti-aging and vitality, an IV infusion allows the cells to circulate throughout the body. They are naturally drawn to areas of inflammation, acting as an intelligent, body-wide repair system.
- Ultrasound-Guided Injections: For orthopedic issues such as arthritis in a knee or a rotator cuff injury, precision is paramount. We use high-resolution ultrasound imaging to guide injections directly into the damaged joint or tissue, ensuring the cells are placed exactly where they are needed most.
To learn more about how we design these protocols, explore detailed information on our main stem cell therapy treatments. This personalized approach ensures that your therapy is optimized for safety, comfort, and the best possible clinical results.
Proven Clinical Applications of Stem Cell Therapy
While the science behind regenerative medicine is extraordinary, its true value is measured in patient outcomes. The application of stem cell therapies has moved beyond theory and is now utilized to solve specific health challenges—restoring function, reducing pain, and elevating overall quality of life.
These are not broad, speculative treatments. They are highly targeted therapies with clear objectives, grounded in the unique signaling and repair capabilities of stem cells.
From restoring mobility in a degenerative knee to calming the systemic inflammation of chronic disease, this approach is fundamentally changing what was once thought possible in medicine. The focus is on activating the body's own repair mechanisms to achieve lasting biological change. We are not just managing symptoms; we are aiming to resolve the root conditions causing them.
This flowchart illustrates the fundamental process of regenerative therapies, showing how we progress from primary cell sources to the powerful messengers that orchestrate healing and repair.

As you can see, potent MSCs are derived from primary sources, and they in turn produce exosomes—the tiny packages carrying vital instructions for tissue regeneration and immune modulation.
Orthopaedics and Sports Medicine
One of the most well-established applications for stem cell therapy is in orthopedics, where it offers a powerful alternative for joint pain and tissue injuries. For conditions like osteoarthritis, which is the progressive degradation of cartilage, this approach can be transformative.
The strategy here is twofold. First, the potent anti-inflammatory signals from Mesenchymal Stem Cells (MSCs) work to calm the chronic inflammation that drives both pain and progressive cartilage damage. Second, these cells release a cascade of growth factors that signal your own local cells to begin rebuilding, improving joint function and mobility from within.
For athletes and active individuals, these therapies can dramatically accelerate recovery from common injuries like:
- Tendonitis and ligament sprains
- Muscle tears
- Degenerative disc conditions
By focusing on true tissue regeneration instead of merely masking pain, patients often experience more sustainable relief and can postpone—or even avoid—more invasive surgical procedures.
Autoimmune Conditions and Inflammation Management
Autoimmune diseases, such as rheumatoid arthritis or lupus, result from the body's immune system mistakenly attacking healthy tissues. This creates a state of chronic, systemic inflammation that can be debilitating. Stem cell therapy offers a unique approach by addressing the heart of the problem: immune dysregulation.
The goal in treating autoimmune conditions is not to suppress the immune system, but to re-educate it. MSCs are exceptionally adept at this. They act as immune modulators, helping to calm an overactive response and restore balance, which in turn reduces the body's self-inflicted damage.
Delivered via systemic IV infusions, the stem cells circulate throughout the body and are naturally drawn to sites of inflammation. Upon arrival, they work to down-regulate inflammatory signals and foster a healing environment. For patients managing these complex conditions, this can translate to a significant reduction in symptoms and a profound improvement in their quality of life.
Longevity and Proactive Anti-Ageing
Beyond treating specific diseases, stem cell therapies are a foundational tool in advanced longevity medicine. As we age, our personal supply of stem cells diminishes, and their regenerative capacity declines. This cellular decline is a primary driver of the aging process, leading to reduced energy, slower recovery, and greater susceptibility to age-related conditions.
The therapeutic goal here is to proactively replenish the body's reservoir of these critical repair cells. By introducing a potent dose of young, vibrant allogeneic MSCs, we can amplify the body’s ability to repair itself at a cellular level. This systemic revitalization helps improve overall vitality, boost energy levels, and strengthen resilience against the insults of aging. It is a proactive strategy designed to extend your healthspan—the years you live in optimal health—so you can maintain high performance and enjoy an enhanced quality of life, for longer.
Your Regenerative Journey with Us
Choosing to embark on a regenerative treatment plan is a significant decision. We believe the entire experience should feel as restorative as the therapy itself. Your journey with us is a seamless, physician-led process designed around your unique biology and clinical needs, all while prioritizing your personal comfort. It is a partnership built on trust, transparency, and an unwavering commitment to excellence.
From your initial consultation, our focus is squarely on you. We move beyond one-size-fits-all protocols to create a therapeutic strategy that is meticulously aligned with your specific health goals. This is the foundation of everything we do.
A Physician-Led, Data-Driven Process
Your path to regeneration begins with a detailed consultation with one of our specialist physicians. This is a comprehensive discovery process where we take the time to listen to your history, understand your objectives, and begin to map out a potential course of action.
This initial conversation is followed by advanced diagnostics. We use a suite of world-class tools—from AI-enhanced full-body MRIs to precise laboratory testing—to create an incredibly detailed picture of your current biological state. This data-rich approach allows our medical team to design a stem cell therapies protocol that is not just personalized, but precise.
Uncompromising Standards of Safety and Quality
Clinical excellence demands an absolute dedication to safety and quality. At the heart of our institute is a state-of-the-art biotechnology laboratory that operates under the highest international and national standards. This facility is where we ensure the purity, viability, and potency of every cellular product we administer.
Our laboratory is fully COFEPRIS-licensed and ISO-certified, a testament to our commitment to meeting rigorous regulatory benchmarks. This guarantees that every step of cell processing—from sourcing to administration—is handled with uncompromising sterile technique and scientific precision.
This level of oversight is critical for patient safety. Mexico's regulatory framework for stem cell therapies is a multi-tiered system designed to protect patients while enabling therapeutic access. COFEPRIS (Comisión Federal para la Protección contra Riesgos Sanitarios) is the primary federal regulator, mandating strict approvals and committee oversight for any legitimate use of advanced cell therapies. You can discover more insights about this robust regulatory landscape on ISCT Global.
An Integrative and Supportive Approach
We understand that the best results occur when stem cell therapies are supported by a holistic framework. True regeneration is a systemic process, which is why we integrate complementary modalities to enhance your body’s healing environment.
Your protocol may include supportive treatments designed to amplify cellular function and accelerate recovery, such as:
- Hyperbaric Oxygen Therapy (HBOT) to increase oxygen saturation in tissues, promoting cellular repair.
- IV Nutritional Infusions to deliver essential vitamins and minerals directly to your cells, optimizing their function.
From coordinating your medical travel logistics with our dedicated concierge team to providing compassionate, continuous follow-up care after your procedures, our entire team is here to support you. We manage all the details so you can focus completely on your health and restoration in a calm, restorative, and luxurious setting.
Understanding Treatment Costs and Medical Travel
Making a commitment to your long-term health is one of the most important investments you will ever make. We also understand that trust and confidence are built on clarity, especially regarding the practical aspects of your care. That is why we are completely transparent about the cost of our stem cell therapies, so you know exactly what to expect from day one.
A significant factor for our international patients is the exceptional value they find here in Mexico. We provide access to world-class regenerative medicine without the prohibitive price tags common in other countries, particularly the United States. This is not a reflection of compromised quality, but rather a more sensible healthcare model.
The Financial Advantage of Care in Mexico
Choosing to receive your treatment with us unlocks significant cost savings. Data from 2025 shows that stem cell therapies in Mexico consistently cost 50–65% less than in the U.S. For example, orthopedic treatments average $3,500–$8,000 per joint here, while the same procedures can range from $7,000–$20,000 in the States. The disparity is even wider for systemic treatments, which can be 55–65% less. You can see a full breakdown of these figures in Medical Tourism Magazine's stem cell treatment cost comparison.
This means you can afford a truly comprehensive, physician-led regenerative protocol—often including the supportive therapies needed to achieve the best possible results—for a fraction of what a more basic treatment might cost elsewhere.
Our pricing is straightforward and all-inclusive, covering your personalized treatment plan, all physician consultations, and every necessary clinical procedure. There are no hidden fees or surprises. This allows you to plan your investment with confidence and focus your energy entirely on your health.
A Seamless and Restorative Medical Journey
We recognize that the idea of traveling for medical care can seem daunting. That is precisely why we have designed a seamless, concierge-style medical travel experience to eliminate stress from the equation. Our patient care team handles every logistic, allowing you to simply arrive, relax, and focus on healing in the beautiful, restorative setting of Los Cabos.
Our all-inclusive medical travel coordination includes:
- Luxury Accommodations: We arrange your stay at one of our premier partner hotels, all chosen for their comfort and relaxing atmosphere.
- Private Transportation: From the moment you land at the airport to all your clinic appointments, our professional, private drivers will handle all your ground transport.
- Personalized Itinerary: Your entire schedule is thoughtfully organized to create a smooth, effortless, and stress-free experience from start to finish.
Our goal is simple: to create an environment where your only priority is your well-being. By managing all the details with care and precision, we ensure your regenerative journey is as peaceful as it is powerful. You can learn more about what makes us the best licensed stem cell clinic in Mexico and see how our patient-first approach is setting a new standard.
Your Questions About Stem Cell Therapy Answered
Exploring regenerative medicine is an important step, and it is natural to have questions. This section is designed to provide clear, straightforward answers to the inquiries our patients most frequently have about stem cell therapy, so you can feel confident and informed about the path ahead.
We believe a well-informed patient is an empowered one. Our commitment is to complete transparency, ensuring you feel secure and knowledgeable at every point in your health journey.
Are Stem Cell Therapies Safe?
Safety is the absolute foundation of everything we do. We operate under the strictest international and national standards, beginning with how we source our cells. All allogeneic cells come from meticulously pre-screened, healthy donors and are processed in our in-house, COFEPRIS-licensed and ISO-certified laboratory. This guarantees their purity, potency, and viability.
Every procedure is performed by a specialist physician within a sterile clinical environment. While any medical treatment carries potential risks, such as temporary soreness at an injection site, our rigorous quality control and expert medical oversight are in place to minimize any possibility of a reaction and protect your well-being.
How Long Until I See Results?
The timeline for results is highly individual and depends on your specific condition, your body's response, and your treatment objectives. The regenerative process is not instantaneous; it unfolds as your body’s own repair mechanisms are activated.
Many of our patients report initial improvements—such as a greater sense of well-being and reduced inflammation—within the first few weeks. True tissue regeneration, such as rebuilding cartilage in a joint, is a more gradual process. The most significant and lasting improvements are typically observed over the course of three to six months as the new tissue fully matures.
Your medical team will provide a personalized outlook based on your diagnostic results and will closely monitor your progress throughout your journey.
Who Is an Ideal Candidate for This Therapy?
Individuals who experience the most benefit are typically those seeking to address the biological root cause of a chronic condition, accelerate recovery from an injury, or proactively invest in their long-term health and vitality. However, candidacy is determined through a comprehensive medical evaluation, not a simple checklist.
This evaluation includes a thorough review of your medical history, supported by advanced diagnostic imaging and laboratory analysis. It allows our physicians to confirm that stem cell therapies are not just a suitable option, but a genuinely promising one for your specific health goals. It is also important to note that certain conditions, such as an active cancer diagnosis or an acute systemic infection, are contraindications. We screen for these meticulously during your initial assessment.
Ready to discover if regenerative medicine is right for you? Contact Longevity Medical Institute today to schedule your personal consultation and begin your journey toward lasting health.
Schedule Your Consultation at Longevity Medical Institute
Considering Stem Cell Therapy in Mexico?
Mexico has become an important destination for patients seeking regenerative and longevity therapies due to its combination of licensed medical clinics, experienced physicians, and established regulatory oversight.
Longevity Medical Institute provides physician-supervised regenerative care in Mexico using structured clinical protocols and patient screening standards. For international patients, treatment is coordinated to support safety, continuity of care, and informed decision-making throughout the process.
Learn more about regenerative medicine options and patient care in Mexico.
Author
Dr. Kirk Sanford, DC — Founder & CEO, Longevity Medical Institute. Dr. Sanford focuses on patient education in regenerative and longevity medicine, translating complex therapies into clear, practical guidance for patients.
Medical Review
Dr. Félix Porras, MD — Medical Director & Chief of Regenerative Medicine, Longevity Medical Institute. Dr. Porras provides clinical oversight and medical review to help ensure accuracy, safety context, and alignment with current standards of care.
Last Reviewed: January 5, 2026
Short Disclaimer
This information is for educational purposes only and is not medical advice. It does not replace an evaluation by a qualified healthcare professional. For personalized guidance, please schedule a consultation.